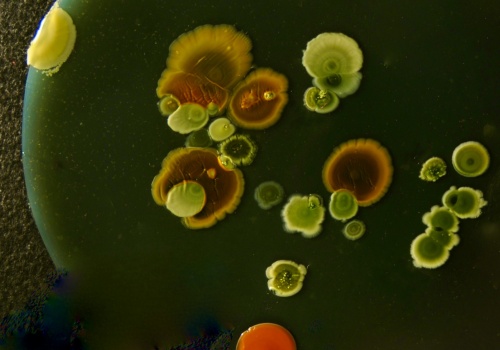
Mikroroboty z bakterii? Najpierw trzeba było sprawdzić, czy ich kompas naprawdę daje radę

Kiedy myślisz o kompasie, widzisz igłę, mapę i człowieka, który próbuje nie zgubić się w lesie. Tymczasem niektóre bakterie noszą kompas w środku i to dosłownie. W ich wnętrzu działa miniaturowy układ zbudowany z magnetycznych nanocząstek, który ustawia całą komórkę tak, jak igłę w polu magnetycznym...
źródło: https://www.focus.pl/artykul/mikroroboty-z-bakterii-najpierw-trzeba-bylo-sprawdzic-czy-ich-kompas-naprawde-daje-rade
dodano: 2026-02-20 11:36:06
Inne znaleziska:
Mikroroboty nowej generacji wykorzystują enzymy do terapii celowanej w leczeniu nowotworów
Mikroroboty nowej generacji wykorzystują enzymy do terapii celowanej w leczeniu nowotworów
Proste roboty z mikropęcherzyków, napędzane enzymami, samodzielnie trafiają do guzów i uwalniają leki na żądanie, zwiększając skuteczność terapii. Artykuł Mikroroboty nowej generacji wykorzystują enzymy do terapii celowanej w leczeniu nowotworów poch...
alertmedyczny.pl,
2026-02-04 06:21:05
2026-02-04 06:21:05
Laser, ciecz i nanocząstki. Tak powstają mikroroboty przyszłości
Laser, ciecz i nanocząstki. Tak powstają mikroroboty przyszłości
Nowa technika druku 3D pozwala „składać” mikroskopijne struktury z metalu i nanomateriałów. To krok w stronę mikrorobotów, które mogłyby kiedyś pływać w naszej krwi, dostarczać leki i wspierać diagnostykę na niespotykaną dotąd skalę.
holistic.news,
2026-02-10 12:10:10
2026-02-10 12:10:10
Zamknięto naturalne baseny El Caletón z powodu bakterii
Zamknięto naturalne baseny El Caletón z powodu bakterii
Popularne naturalne baseny El Caletón w Garachico zostały tymczasowo zamknięte dla kąpielących się po wykryciu przekroczenia dopuszczalnych norm bakterii E.coli. Urząd miasta przeprowadza dodatkowe analizy i kontrole systemu kanalizacyjnego, aby usta...
wyspykanaryjskie.info,
2025-08-20 10:09:09
2025-08-20 10:09:09
Jeden nie boi się sierści, a drugi bakterii. Nowe odkurzacze Dyson
Jeden nie boi się sierści, a drugi bakterii. Nowe odkurzacze Dyson
Dyson pokazał w Berlinie swój najmocniejszy odkurzacz pionowy, najsmuklejszy odkurzacz pionowy i wcale nie odkurzacz pionowy.Przeczytaj pełny artykuł tutaj: Jeden nie boi się sierści, a drugi bakterii. Nowe odkurzacze Dyson
tabletowo.pl,
2025-09-08 09:10:18
2025-09-08 09:10:18
Warszawska Praga nie zawiodła. "Kuchenne rewolucje" pełne "rupieci, brudu, syfu i bakterii"
Warszawska Praga nie zawiodła. "Kuchenne rewolucje" pełne "rupieci, brudu, syfu i bakterii"
Bar Alpejski — to brzmi dumnie, jednak to, co zastała na miejscu Magda Gessler przypominało horror. Warszawska restauracja przywitała restauratorkę wszechobecnych brudem, PRL-em i kucharzem, który pracował "od dwóch godzin". Na domiar złego matka wła...
plejada.pl,
2025-10-16 23:27:04
2025-10-16 23:27:04
Kuchnia pełna bakterii i wirusów. 5 sposobów, by uniknąć zakażenia
Kuchnia pełna bakterii i wirusów. 5 sposobów, by uniknąć zakażenia
Zarazki czają się w każdym domu. Ich obecność w kuchni jest szczególnie niebezpieczna dla zdrowia, ze względu na kontakt z żywnością. Eksperci kampanii #Safe2EatEU („Jedz bezpiecznie”) przypominają, że proste, codzienne nawyki mogą uchronić nas przed...
rmf24.pl,
2025-10-17 17:11:06
2025-10-17 17:11:06
Globalne ocieplenie otwiera drzwi śmiertelnej bakterii. Jest w Bałtyku
Globalne ocieplenie otwiera drzwi śmiertelnej bakterii. Jest w Bałtyku
Władze Luizjany poinformowały, że w tym roku zmarło już pięć osób w wyniku zakażenia bakterią zjadającą ludzkie ciało – Vibrio vulnificus. To wyjątkowo niebezpieczny patogen, który w ostatnich latach staje się coraz większym zagrożeniem, głównie z po...
smoglab.pl,
2025-10-22 08:00:10
2025-10-22 08:00:10
GIS ostrzega: Lidl wycofuje boczek z powodu bakterii
GIS ostrzega: Lidl wycofuje boczek z powodu bakterii
Główny Inspektorat Sanitarny wydał w piątek ostrzeżenie przed partią boczku rolowanego w plastrach, w której stwierdzono obecność bakterii Listeria monocytogenes. Spożycie żywności zanieczyszczonej bakterią może prowadzić do choroby zwanej listeriozą...
portalspozywczy.pl,
2025-11-14 22:39:37
2025-11-14 22:39:37
Naukowcy odkryli ukrytą słabość bakterii boreliozy. Mangan może być kluczem do nowych terapii
Naukowcy odkryli ukrytą słabość bakterii boreliozy. Mangan może być kluczem do nowych terapii
Badacze odsłonili ukrytą słabość B. burgdorferi. Mangan, jej kluczowy pierwiastek obronny, może stać się podstawą nowych terapii boreliozy. Artykuł Naukowcy odkryli ukrytą słabość bakterii boreliozy. Mangan może być kluczem do nowych terapii pochodzi...
alertmedyczny.pl,
2025-11-23 02:04:32
2025-11-23 02:04:32
Każdy go dotyka, mało kto myje. Pilot do TV to raj dla bakterii
Każdy go dotyka, mało kto myje. Pilot do TV to raj dla bakterii
Pilot do telewizora gromadzi bakterie, wirusy i tłuszcz z dłoni. Wyjaśniamy, co na nim żyje, jak często go dezynfekować i czym czyścić, by nie zniszczyć napisów.
wprost.pl,
2025-12-16 07:50:12
2025-12-16 07:50:12